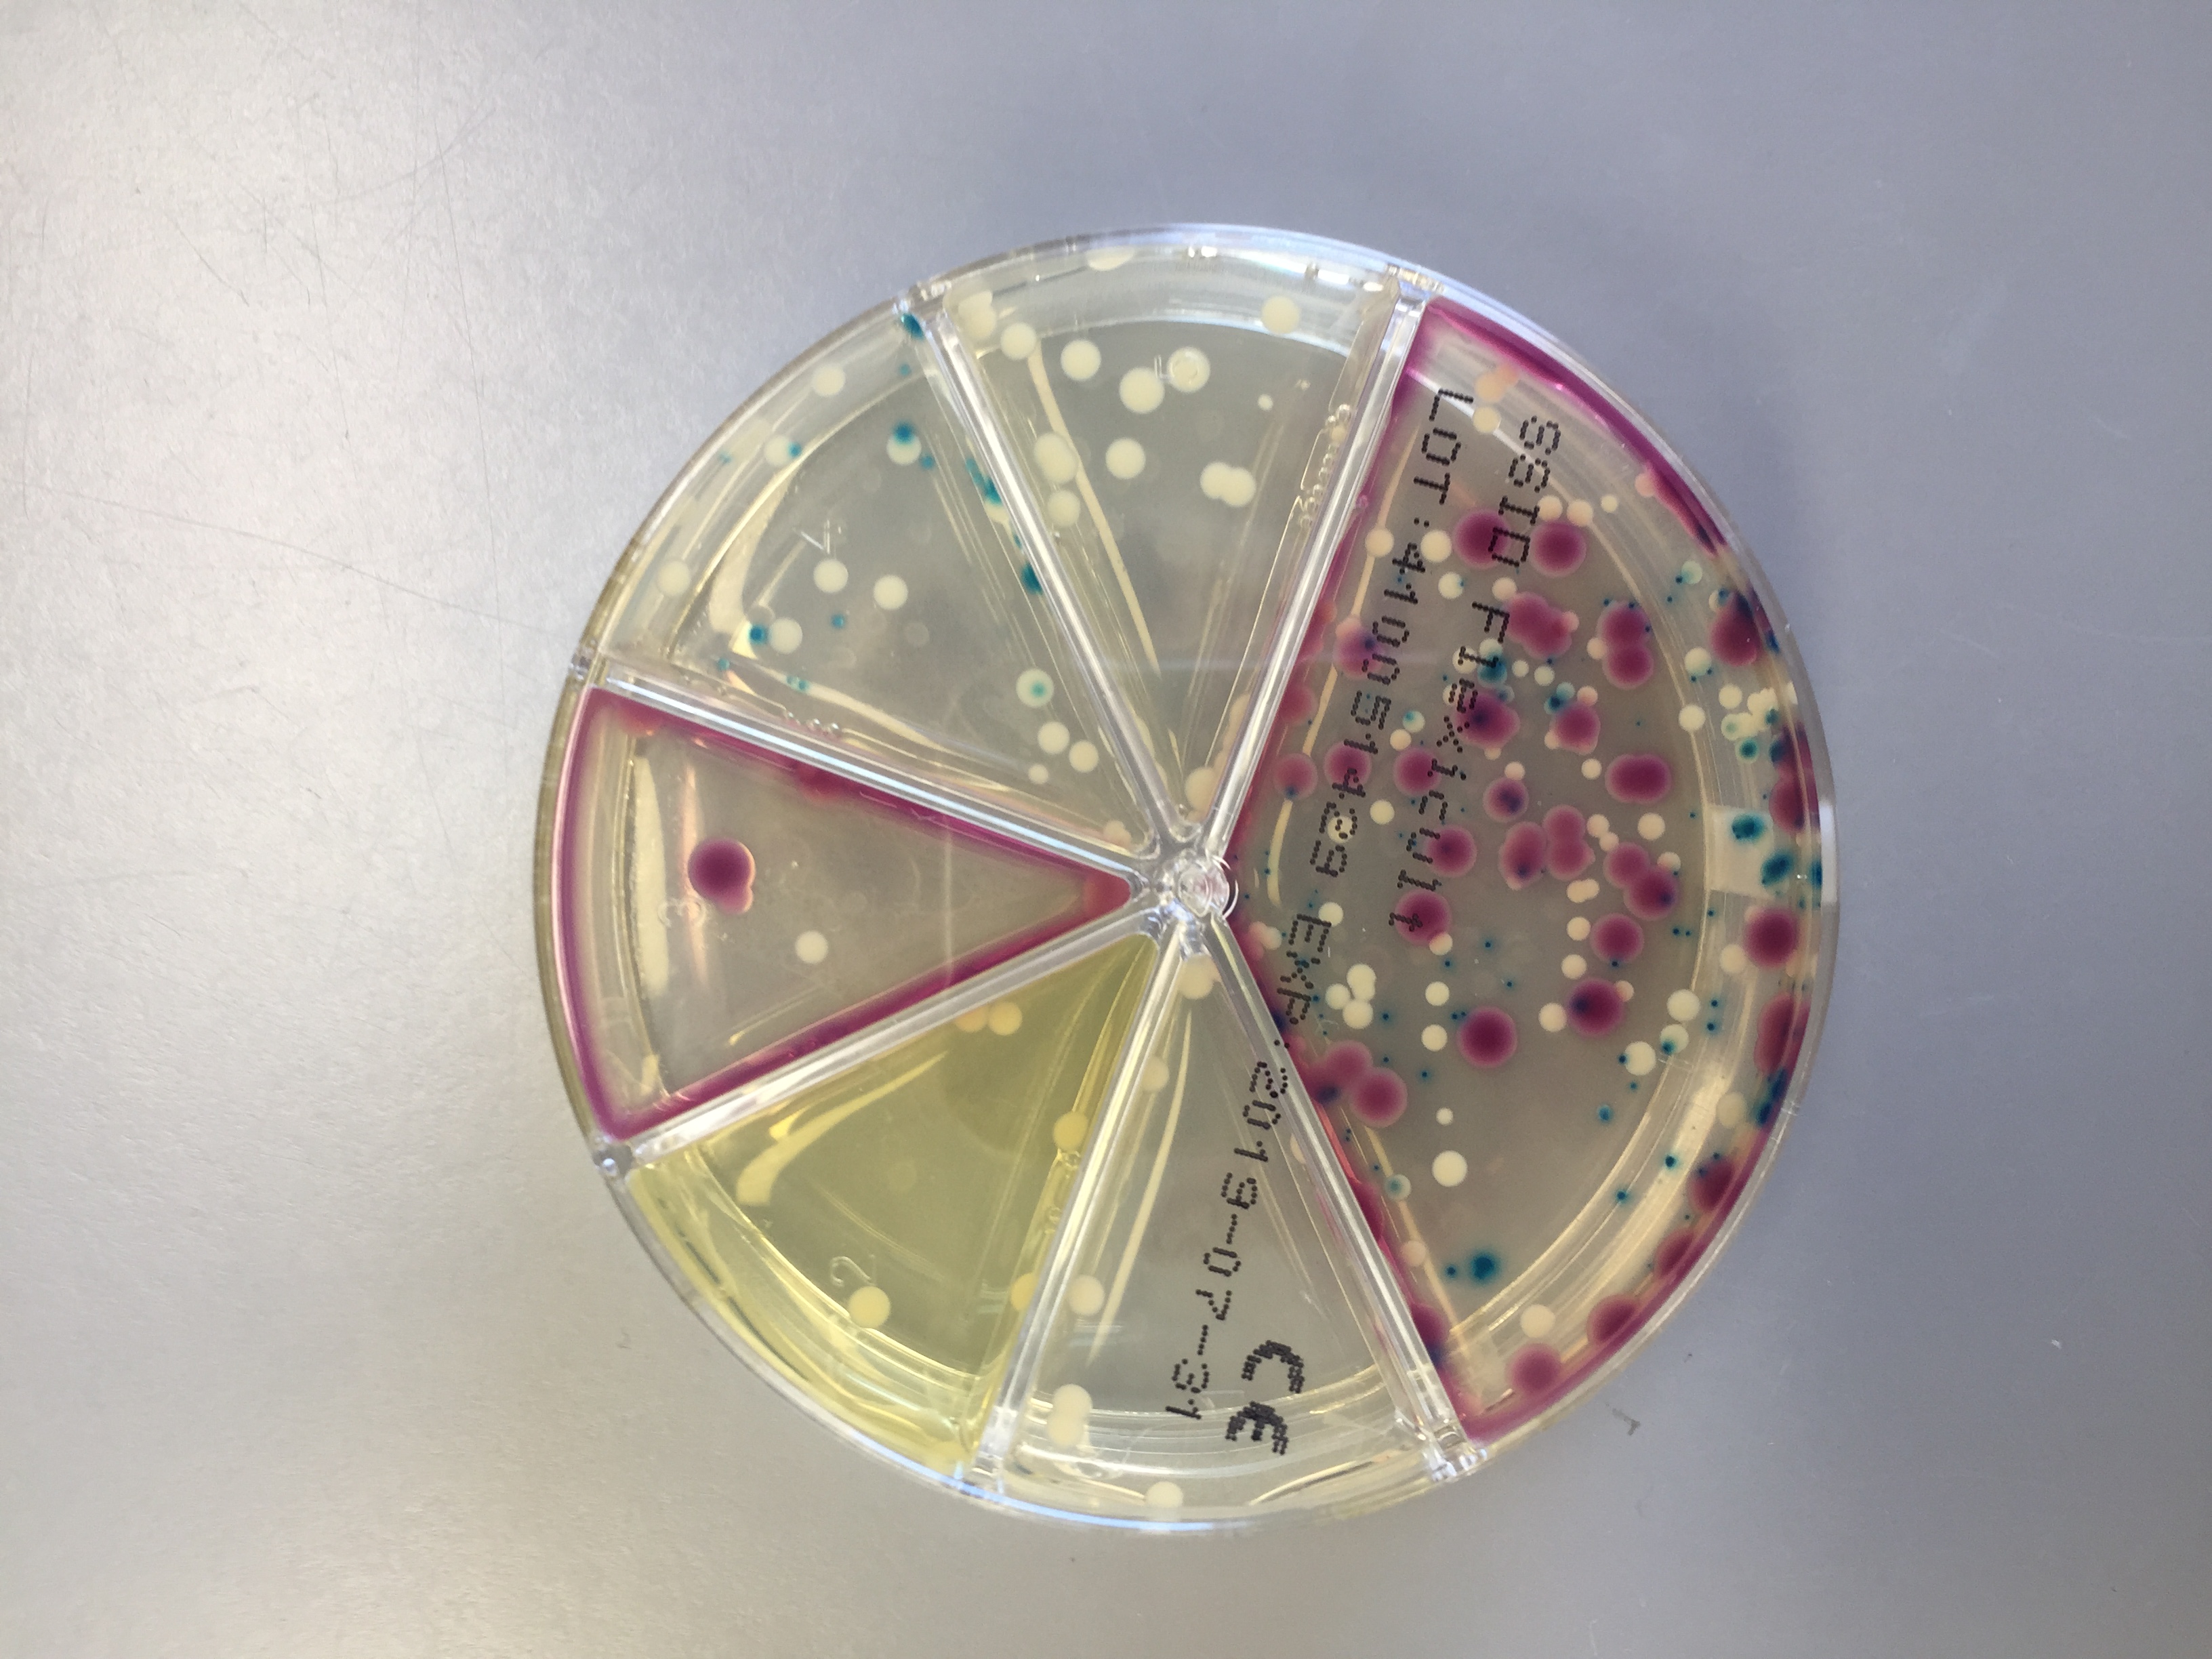
Image3

"Vi har vandret i fjeldet. Det er så smukt, og vejret her generelt været rigtig fint, mens vi har været her. Vi køber det skønneste fisk på “Brættet” nede ved havnen. Det er billigt, og dagens fangst er lige hevet op af det klare vand".

Headline
Det er meget forskellige opgaver, man møder. Børn, voksne, gravide, psykisk syge, diskusprolaps, cancer patienter, diverse skadestuearbejde, selvmordsforsøg og meget andet. Det kræver noget is i maven og en god evne til at søge viden

Sygeplejersker i Maniitsoq
Vi er to sygeplejersker, der har taget et 3 måneders vikariat ved Maniitsoq Sundhedscenter. Vi er faldet godt til og har fået en fantastisk flot lejlighed.
Vores nye kollegaer på sundhedscentret er rigtig søde, og vi er blevet taget godt imod.
Vi oplever begge, at vi kan bruge vores kompetencer på en god måde. Der er meget at lære, men også meget man kan. Anne er i sengeafdelingen og Lene i skadestue/ambulatoriet. Vi er fem sygeplejersker i afdelingen, og der er to i ambulatoriet. Der er lidt overlap lige nu, så der er et par stykker, der snart rejser hjem.
Det er meget forskellige opgaver, man møder. Børn, voksne, gravide, psykisk syge, diskusprolaps, cancer patienter, diverse skadestuearbejde, selvmordsforsøg og meget andet. Det kræver noget is i maven og en god evne til at søge viden. Men det er et veldrevet sted, og der er altid nogen, man kan spørge eller ringe til. Stedet er normeret til 2 ½ lægestilling, så der er altid læger her.
Mange henvender sig på telefonen med alverdens ting, og man er jo også 112, hvis der sker noget i byen. Det er rigtig spændende, og tvinger en til at tænke sig rigtig godt om indenfor de rammer, vi har.
Byen er lille, og man møder sine patienter i byen om eftermiddagen. Der er jo ikke så mange, der har bil, så alle går rundt.
I sidste uge blev der holdt grillfest til frokost på sundhedscentret. Det var både for personale og patienter.
Børnene springer rundt på klipperne og spiller fodbold på den lille fodboldbane tæt på os.
Vi har vandret i fjeldet. Det er så smukt, og vejret her generelt været rigtig fint, mens vi har været her. Vi køber det skønneste fisk på “Brættet” nede ved havnen. Det er billigt, og dagens fangst er lige hevet op af det klare vand.
I byen er der et godt netværk, og vi er inviteret til at mødes med andre, der arbejder her i byen. Det er meget hyggeligt.
Når man har været i aftenvagt bliver man kørt hjem af portører i ambulancen, og man bliver også hentet, når man er på tilkald om natten.
Lene har arbejdet i Grønland to gange tidligere, for Anne er det første gang, men nok ikke den sidste.
Vi kan kun anbefale at tage afsted, hvis man har lyst til at arbejde meget bredt i sygeplejen, er selvstændig og har mod på at lære. Vi kan garantere, at man får de bedste kolleger her i huset.
Sygeplejerske Lene & sygeplejerske Anne